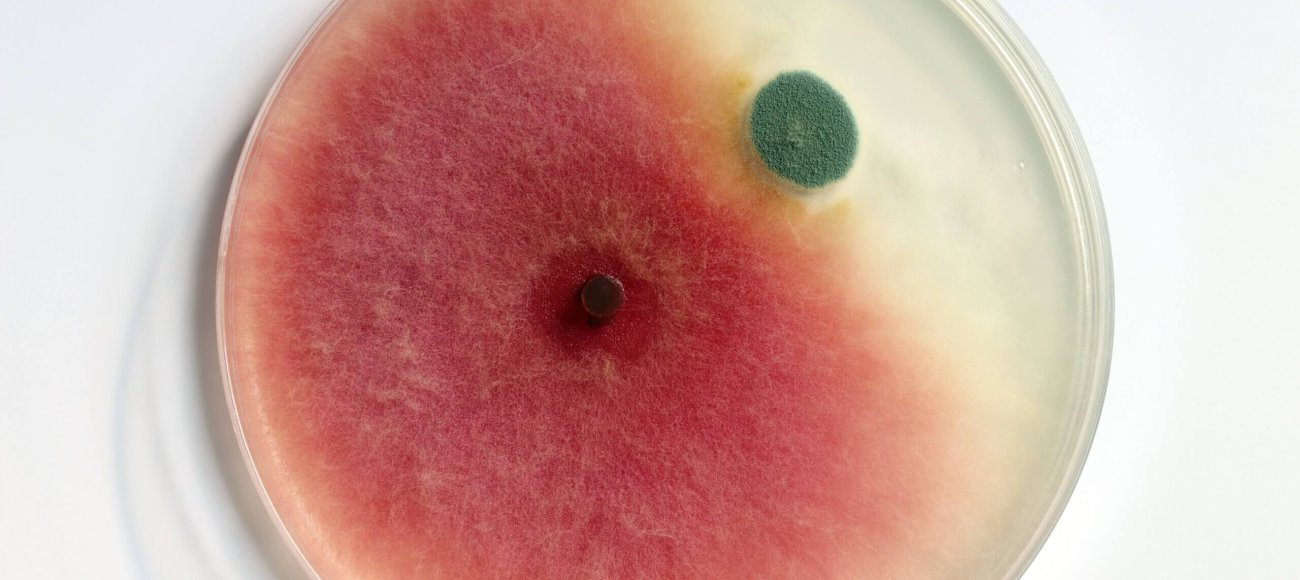
mold and mildew resistant in fabric

Microscopic spores of fungi and bacteria are always present in the air. Mold will grow on cellulose, including cotton and linen, if the Relative Humidity (RH) level reaches over 80% in stagnant air. At the RH of above 92%, wool, and silk will also be harmed by it. Harm due to mold and mildew has become a very concerning issue both for industrial and consumer applications. These fungi grow well in warm, moist conditions; hence, textiles, especially those exposed to these conditions, are particularly susceptible. Besides producing unsightly stains and unpleasant odors, mold and mildew can degrade structural properties in fabrics and pose serious health risks. Therefore, the development and use of fabrics resistant to mold and mildew become a necessity for various industries like healthcare, home textiles, or outdoor gear. This article discusses the relevant science in terms of the protective measures, diversity of applications, and rigorous mold and mildew-resistant fabric testing required to make such claims.
Understanding Mold and Mildew
Mold and mildew are both fungi that thrive in warm, damp environments. Although often used interchangeably, they are distinct in their characteristics. Mold appears in various colors, such as black, green, and yellow, and has a fuzzy texture. Mildew, a specific type of mold, typically presents as a white or gray powdery growth, often found on surfaces like fabrics, paper, and leather.
How Mold and Mildew Affect Fabrics
Both mold and mildew are fungal spores that can have detrimental effects on fabrics, affecting their appearance, durability, and safety. Below is a comprehensive illustration of how these microbes affect textiles:
Material degradation
Mold and mildew obtain nourishment by feeding on organic matter in fabrics, particularly of cotton, linen, and wool. While they grow, they start decomposing fibers, thus weakening the material’s strength or structural integrity. The accumulation of fibers can make the fabric rip more easily and may leave it stretched out or even unusable over time.
Staining and discoloration
One of the most noticeable effects of mold and mildew on fabrics is staining. Mold appears as dark, patchy spots in different colors such as black, green, or brown whereas mildew is usually a lighter powdery growth, often in whites or greys. These stains are usually so stubborn that they become hard to get rid of and as such may damage the garment by making marks on it that cannot be removed. Mold-related staining can make fabric visually unappealing.
Unpleasant odors
Molds and mildew have musty odors, arising from their growth and metabolic breakdown of organic matter. Such odors may impregnate fabrics further and render them unusable or uncomfortable to wear. In some cases, the smell cannot be washed off, especially if mold has deeply invaded the fibers.
Health risks
Fabrics that are infested with mold and mildew can be extremely hazardous to health. The mold spores, when released into the air and inhaled, can cause respiratory problems, allergic reactions, and other health issues-especially for those having a compromised immune system. Some molds will produce mycotoxins which are toxic compounds that can cause more severe health effects upon prolonged exposure. However, to minimize these risks, mold and mildew-resistant fabric may be used.
The Science Behind Mold and Mildew Resistance in Fabrics
Antifungal Treatments:
Various antifungal treatments are developed against fungal growth on fabrics to keep up the integrity of fabrics thereby extending their lives in moist environments. Some common and effective antifungal treatments applied on fabrics are discussed below:
Quaternary Ammonium Compoun
- Quaternary ammonium compounds, more popularly known as QACs, are one class of chemicals that find very wide application in textiles as antifungal agents. These work by disrupting the fungal cell membrane, leading to cell death and hence preventing the colonization of mold and mildew on the fabric. QACs are normally applied as surface treatments-a protective barrier that inhibits the growth of fungi. Rigorous mold and mildew-resistant fabric testing is essential to ensure that the application of QACs is effective in providing long-term protection against fungal contamination in textiles.
Silver Nanoparticles
- Silver nanoparticles have increasingly begun to find their use in textile industries because of the strong antimicrobial and antifungal properties that they exhibit. This is because the nanoparticles inhibit mold and mildew growth by disrupting vital cellular processes in fungi, hence leading to their death. The incorporation is of two ways: one is during the fabric manufacture, and the other involves the application as a surface coating. Fabrics treated with silver find widespread application in areas like medical textiles and sportswear where hygiene and microbial resistance are of the essence. mold and mildew–resistant fabric testing is crucial to ensure that silver-treated fabrics provide effective and long-lasting protection against fungal contamination.
Incorporating Mold and Mildew Resistance into Fabric Production
- Incorporating mold and mildew resistance into fabric production involves integrating antifungal properties directly into the fabric during the manufacturing process. This could either be a preservative applied to the polymer melt during fiber extrusion or later as a surface treatment after weaving. Such treatments ensure that the fabric is inherently resistant to mold and mildew, providing extended protection throughout the life of the fabric. Embedding antifungal properties right into the fabric means manufacturers can create textiles that are even more hygienic, and suitable for application in wet conditions. This integration is quite important for industries such as healthcare, outdoor gear, and home textiles, where fabric integrity and safety are paramount. mold and mildew-resistant fabric testing is required to prove these integrated properties.
Testing and Validation of Mold and Mildew Resistant Fabric
Ensuring Efficacy Through Rigorous Testing
While the development of mold- and mildew-resistant fabrics is a significant advancement, ensuring their effectiveness through rigorous mold- and mildew-resistant fabric testing is even more essential. Testing not only confirms the effectiveness of antifungal treatments but also ensures that the fabric meets industry standards for safety and performance.
Common Testing Methods
- ASTM G21-15:This standard test method G21-15 addresses the fungal resistance of synthetic polymeric materials. Fabrics are placed in a controlled fungal environment and evaluated for their resistance to growth.
- AATCC 30: This test method evaluates the antifungal activity of textiles. Fabrics are incubated with fungal spores, and the degree of fungal growth is measured over time.
Application of Mold and mildew-resistant fabrics:
Mold- and mildew-resistant fabrics play an important role in industries that are regularly exposed to moisture and humidity. In addition to preventing the growth of fungi, these fabrics provide durability, hygiene, and safety. It includes
Healthcare Industry
Sterility is an important attribute in the healthcare environment predominantly for infection control and patient safety. Broad applications of antimicrobial fabrics resistant to mold and mildew in a hospital environment include bedding, curtains, and upholstery. These particular fabrics reduce the level of nosocomial infections by preventing fungal growth when exposed to moisture and body fluids. Mold and mildew-resistant fabric testing is extremely important as such fabrics should meet very stringent requirements for hygiene in medical institutions.
Home Textiles
In residential settings, mold and mildew-resistant fabrics are particularly valuable in moisture-prone areas such as bathrooms and kitchens. Products like shower curtains, bath mats, and kitchen towels often come into contact with water and humidity, making them susceptible to mold and mildew. By using fabrics treated with antifungal agents, homeowners can prevent the growth of fungi, thereby extending the life of these textiles and maintaining a healthier living environment
Hospitality Industry
The hospitality industry requires a high degree of cleanliness and durability for textiles in hotels, restaurants, and other establishments used for serving. Mold- and mildew-resistant fabrics used in bedding, curtains, upholsteries, and towels reduce fungal development in these areas when atmospheric moisture fluctuates. However, this effectiveness needs to be verified through rigorous mold and mildew-resistant fabric testing.
Mold and Mildew-Resistant fabric testing with MIS
The resistance properties against mold and mildew in textiles are very important, from health to home textile applications. The development of effective antifungal treatments and integration with fabric production for resistance properties are crucial steps that maintain the life span of textiles. However, the efficacy of these treatments must be verified through rigorous mold and mildew-resistant fabric testing.
At Microbial Investigations Switzerland (MIS) we provide advanced testing and validation services that ensure your fabrics maintain the highest standards of protection against fungi. With MIS, one can assess the quality and longevity of textiles and give assurance to the customers. Contact us today to learn more about our services